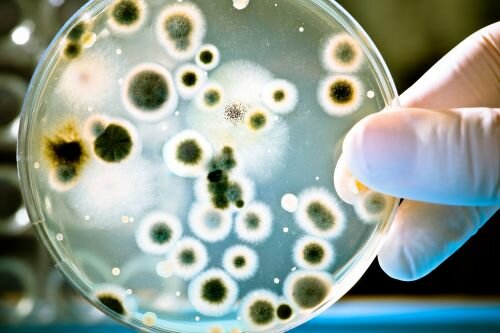
9.Descubrimiento de microorganismos

-
 Fue el primer modelo de explicación sobre la enfermedad, a causa y acciones de fuerzas intangibles, invisibles y misteriosas. Según este modelo la enfermedad se podía curar con ritos, sahumerios, mezcla de hierbas y algunas prácticas de limpieza.
Fue el primer modelo de explicación sobre la enfermedad, a causa y acciones de fuerzas intangibles, invisibles y misteriosas. Según este modelo la enfermedad se podía curar con ritos, sahumerios, mezcla de hierbas y algunas prácticas de limpieza. -
 la aparición, desarrollo y terminación de las enfermedades se atribuyo a seres superiores conocidos como dioses.
la aparición, desarrollo y terminación de las enfermedades se atribuyo a seres superiores conocidos como dioses.
Para curar o eliminar la enfermedad se ofrecían sacrificios y oraciones a los dioses. -
 Según esta teoría la enfermedad es a causa de un desequilibrio de fuerzas. Se fundamenta en el equilibrio de algunas partes del cuerpo así como su cura a partir de la ingesta de sustancias.
Según esta teoría la enfermedad es a causa de un desequilibrio de fuerzas. Se fundamenta en el equilibrio de algunas partes del cuerpo así como su cura a partir de la ingesta de sustancias. -
 Basado en la creencia de la luna, las estrellas y los planetas, según el comportamiento, desarrollo, siembra y cosecha de los cultivos se verían alterados por las etapas o fases de los astros.
Basado en la creencia de la luna, las estrellas y los planetas, según el comportamiento, desarrollo, siembra y cosecha de los cultivos se verían alterados por las etapas o fases de los astros. -
 Esta teoría se fundamento en las falencias de sanidad e higiene como fuente de enfermedades. Las enfermedades se desarrollan a causa de gases generados por descomposición de materia orgánica.
Esta teoría se fundamento en las falencias de sanidad e higiene como fuente de enfermedades. Las enfermedades se desarrollan a causa de gases generados por descomposición de materia orgánica. -
 La enfermedad se refleja tanto en en aspectos físicos como en el rendimiento fisiológico, las enfermedades se clasificaron en internas y externas.
La enfermedad se refleja tanto en en aspectos físicos como en el rendimiento fisiológico, las enfermedades se clasificaron en internas y externas. -
 Esta teoría fue respaldada por estudios realizados en el siglo XVIII, en el cual se identifico un agente (hongo) en el funcionamiento normal en una planta,el cual altero el comportamiento y rendimiento de la misma, más adelante se confirmo dicho hallazgo con estudios y aportes.
Esta teoría fue respaldada por estudios realizados en el siglo XVIII, en el cual se identifico un agente (hongo) en el funcionamiento normal en una planta,el cual altero el comportamiento y rendimiento de la misma, más adelante se confirmo dicho hallazgo con estudios y aportes. -
 Esta teoría planteó que para el manifiesto de la enfermedad es necesaria la presencia del germen o bacteria en el organismo u hospedero, propuesto por Pasteur y Koch. Se ve el germen o bacteria como la causa suficiente y necesaria.
Esta teoría planteó que para el manifiesto de la enfermedad es necesaria la presencia del germen o bacteria en el organismo u hospedero, propuesto por Pasteur y Koch. Se ve el germen o bacteria como la causa suficiente y necesaria. -
se acogen términos como "bacteria" y "microbio", dando explicación a las enfermedades de forma más estructurada.
se acogen términos como "bacteria" y "microbio", dando explicación a las enfermedades de forma más estructurada. -
 Se expone que la razón de la enfermedad es debido a una serie de causas tanto internas como externas, algunas como el ambiente, el clima, la atmósfera, etc.
Se expone que la razón de la enfermedad es debido a una serie de causas tanto internas como externas, algunas como el ambiente, el clima, la atmósfera, etc.
Looking for a timeline maker?
Create timelines for projects, roadmaps, history, lessons, legal cases, and stories with Timetoast. Timetoast is a timeline maker for work, school, research, and stories.
